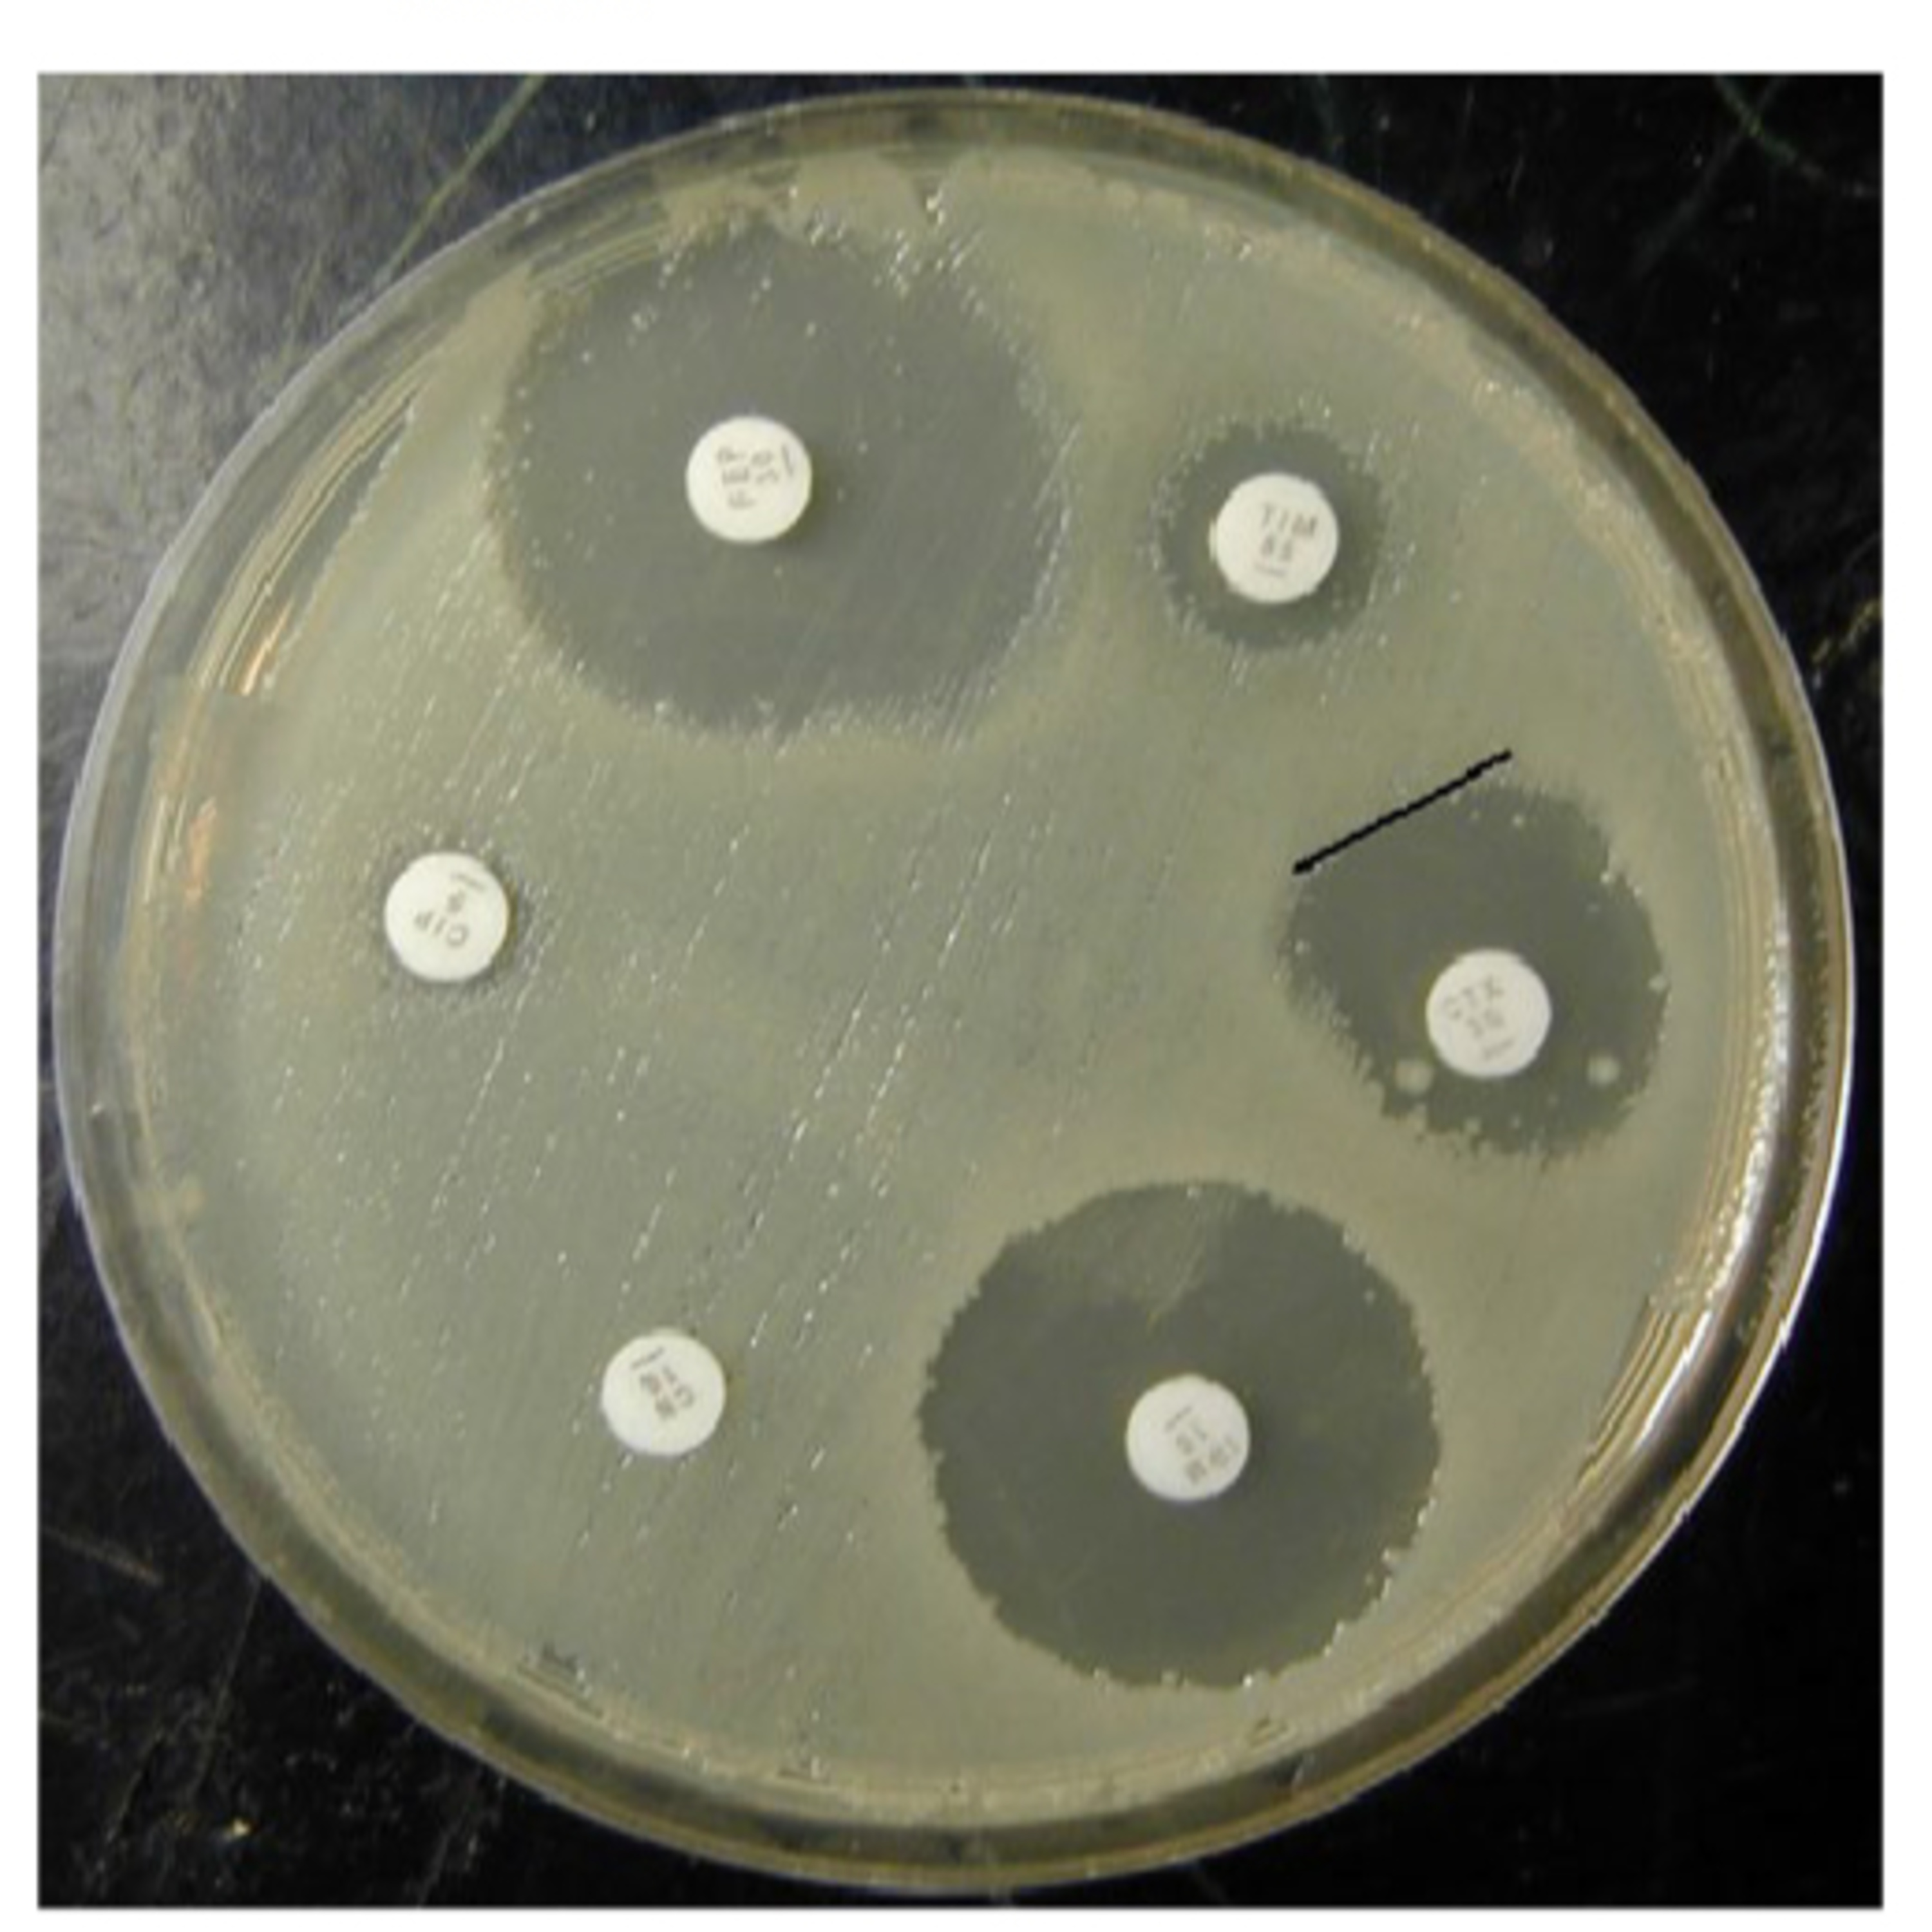

- Hello, my name is (name) and I am a sonographer. I will be performing an ultrasound scan on your (body part) today. This is (name), a medical scribe, who will be documenting the scan for me. He will not interfere with the procedure or ask you any questions. He is here to help me with the paperwork and improve the quality of your care. - Welcome, my name is (name) and I am a sonographer. I will be doing an ultrasound scan on your (body part) today. This is (name), a medical scribe, who will be writing down the details of the scan for me. - Hi, my name is (name) and I am a sonographer. I will be conducting an ultrasound scan on your (body part) today. This is (name), a medical scribe, who will be recording the information of the scan for me. Các bạn hãy lưu ý là từ ngày 5/9/2023 tụi mình bắt đầu mở đăng ký chế độ membership, là chế độ giúp các bạn có thể học tất cả khóa học của Med Lang Fanatic một cách rất tiết kiệm. Tụi mình cũng có chương trình đổi điểm cho các bạn đã và đang là học viên của Med Lang Fanatic. Hãy tham khảo nội dung trên website medlangfanatic.com hoặc liên hệ với tụi mình qua facebook để không bỏ qua cơ hội này nhé.


Podcast Med Lang Fanatic được xuất bản định kỳ vào 20h thứ hai và thứ sáu hằng tuần, là một phần của hệ sinh thái Med Lang Fanatic, đào tạo kỹ năng mềm toàn diện cho sinh viên y dược và nhân viên y tế. Các bạn có thể tham khảo thư viện khóa học cũng như là thư viện đề thi của tụi mình tại trang web medlangfanatic.com http://medlangfanatic.com - **LIE DOWN** ON THE BED/TABLE/COUCH. Ex: "Please lie down on your back" or "Please lie down on your left side". - **ROLL OVER** TO YOUR RIGHT/LEFT SIDE. Ex: "Please roll over to your right side so I can scan your liver". - **LIFT UP** YOUR SHIRT/TOP/DRESS. Ex: "Please lift up your shirt so I can apply some gel on your belly" or "Please lift up your dress so I can scan your pelvis". - **PULL DOWN** YOUR PANTS/SKIRT/SHORTS. Ex: "Please pull down your pants so I can scan your bladder" or "Please pull down your skirt so I can scan your ovaries". - **HOLD STILL** OR **STAY STILL**. Ex: "Please hold still while I take some measurements" or "Please stay still while I capture some images". - **TAKE A DEEP BREATH** AND **HOLD IT**. Ex: "Please take a deep breath and hold it while I scan your gallbladder" or "Please take a deep breath and hold it while I check for blood flow". - **BREATHE OUT** OR **EXHALE**. Ex: "Please breathe out slowly" or "Please exhale gently". - **RELAX** Ex: "Please relax, this will not hurt" or "Please relax, this will be over soon" Các bạn hãy lưu ý là từ ngày 5/9/2023 tụi mình bắt đầu mở đăng ký chế độ membership, là chế độ giúp các bạn có thể học tất cả khóa học của Med Lang Fanatic một cách rất tiết kiệm. Tụi mình cũng có chương trình đổi điểm cho các bạn đã và đang là học viên của Med Lang Fanatic. Hãy tham khảo nội dung trên website medlangfanatic.com hoặc liên hệ với tụi mình qua facebook để không bỏ qua cơ hội này nhé.


Transition là một động từ giúp thể hiện sự thay đổi từ cái này sang cái khác. Một số ví dụ trong bài: - We can transition him from IV to PO furosemide today, and increase his lisinopril from 10 to 20 mg per day. - Immediately after the patient was transitioned to the supine position and muscular relaxants were reversed, she developed generalized seizures. - After this episode, the patient was transitioned to topotecan and bevacizumab with no further seizures to date.


Có mấy công thức nhỏ mà có võ bạn à, hôm nay chúng ta cùng thử công thức nhỏ này để diễn tả những đợt triệu chứng cuối cùng của bệnh nhân nhé. - Nhu động ruột: Peristalsis - Her last bowel movement was about 2 days ago. - His last episode of fever was 3 days ago. Her last menstrual period was 2 weeks ago and normal.


Cấu trúc giúp bạn tư vấn bệnh với bệnh nhân và người nhà, và giảm nguy cơ sót thông tin. - N - Normal anatomy/physiology - W - What is the disease - C - Cause - P - Problems/complications - M- Management


Trong podcast lần này, chúng ta cùng tìm hiểu về một số câu hay và có tính ứng dụng cao mà mình đã gặp khi đọc một bài viết trên trang Healthline.com Một số câu ví dụ trong bài: - But it may not be the quickest route to recovery. - NATA's position statement also noted that the conventional wisdom about icing sprains isn't based on much solid research. - didn't find enough data to say... - Don't ice your ankle for more than 20 minutes at a time. More doesn't equal better in the case of applying ice.


Cách kết hợp giữa Help và một động từ khác có giá trị ứng dụng rất lớn khi chúng ta muốn giải thích những ích lợi của một loại thuốc hay một loại điều trị gì đấy. Bên cạnh đó, cách kết hợp này cũng giúp chúng ta giải thích một số tình trạng sinh lý bình thường khi giải thích về bệnh. Một số ví dụ trong bài: - Mild exercise may help speed recovery after resting for a period of one or two days. - Gentle exercise is good for blood flow and it helps speed up healing. - It may help decrease swelling and pain. - In the ankle, tendons help to maintain stability and strength.

Một số ví dụ trong bài: - Lack of exercise increases susceptibility to disease. - For drugs, the severity of hair loss depends on the drug, its dosage, and the patient's susceptibility. - Susceptibility to disease varies within and across human populations. - antimicrobial susceptibility test - Definitive antibiotic treatment of infective endocarditis is guided by antimicrobial susceptibility testing of the responsible pathogen isolated from clinical cultures.


Một số ví dụ trong bài: - The investigation yielded some unexpected results. - The results yielded some interesting findings. - The results yielded no statistically significant correlation between A and B. - diagnostic yield


Các ví dụ trong bài: - Building in this area of town is restricted. - Membership is restricted to chief executive officers. - Use is restricted to patients who fail to respond to other agents. - Dietary sodium intake should be restricted to 2g/day. - sodium-restricted diet, energy-restricted diet - fluid restriction


Các ví dụ trong bài: - The course required no prior knowledge of Spanish. - prior antibiotic administration - the weeks prior to her death - Patients with thromboembolic events PRIOR TO ADMISSION were excluded.


Ví dụ trong bài: - Disease or medications can compromise patients' mental capacity to provide informed consent. - Immunocompromised patients - Immunocompetent patients - In general, in the setting of severely compromised hemodynamics, it is advisable to be conservative, avoiding potentially toxic loading and maintenance doses of drugs.


Trong văn cảnh y khoa, due thường được sử dụng với nghĩa "expected to happen at a particular time", ví dụ ngày dự sinh là due date. "Their baby is due in January" có nghĩa là "Con của họ dự sinh trong tháng 1". Vậy câu "Stop A and start B when the next A dose is due." có thể dịch là "Ngưng A và bắt đầu B vào giờ dự kiến của cữ A tiếp theo." Ngoài ra due còn gặp trong cụm "due to" nghĩa là "bởi vì".


Tóm tắt nội dung: Có 2 bộ từ vựng hàn lâm y khoa được đề cập: MAVL và MAWL. MAVL có độ phủ gần gấp đôi MAWL với số từ cần phải học ít hơn. Để tìm hiểu thêm về MAVL: https://www.eapfoundation.com/vocab/academic/other/mavl/


Follow trang facebook tại: https://www.facebook.com/MedLangFanatic/ https://www.facebook.com/MedLangFanatic/?__tn__=K-R&eid=ARD0VjkJL-gUrJyzNZQ5oI-FA8prNMeGGCcgTUeCyEil3H8uuLkdn7vz_KRW787sutf70OSnmSz7pTrV&fref=mentions&__xts__%5B0%5D=68.ARBxCpdwfGCB_qZYaSri2DQX63IJgED5AKm4QTtMCR8PVIpk3373hXTQ9j540TKYfGJHSNDcD8n_OoYGIAAWo7TRUa8CZauIYev3fYJ2o0fLe8u-W0sj9EE3L2NJG47ViKtPwXWyWNuQl0FhhfYyp0eMFlf-hHS3QEy7W39K4JXUAQ2cQHMfh7W1--sfwqPsPhj58uENrS8s9O31hsDQr-PNpHhOMkWmnTF0CKYSwsspXsc63CW0qrWPhObnvs-llOlXyomYkd2-YxqrQVrc8LbmG39TqUhaRmBpfHCAJsTfzk75g5_3h0_E2VMPp2yrbyhE73f3vZMeJ3Q453rQ20O7KAWI


Các cặp từ trong bài: - Edema - Swelling - Dysmenorrhea - painful periods - Productive cough - coughing up phlegm - Intermittent claudication - cramp in the muscles which comes and goes Từ khóa để tìm kiếm thư viện 1100 từ của đại học Michigan: Plain language medical dictionary university of Michigan


Các cặp từ trong bài: - Epistaxis - Nose bleeding - Amenorrhea - absence of menses - Arthralgia - joint pain - Dyspnea - shortness of breath - Adenopathy - swollen lymph nodes - Emesis - vomiting - Anorexia - lack of appetite - Anticonvulsant - drugs used to prevent seizures


Một số từ vựng trong bài: - Lay terms (everyday terms) - Lay people - Health literacy - Technical terms (jargons) - Abdomen = belly = tummy - Thorax = chest - Umbilicus = navel




Chúng ta có 2 động từ quan trọng là SHOW và REVEAL. Hầu hết các trường hợp mô tả kết quả xét nghiệm hay kết quả hình ảnh học, chúng ta chỉ cần dùng các cấu trúc câu đơn giản với 2 động từ quan trọng này. Ví dụ: * SHOW: “The chest x-rays SHOWS a left lower opacity.” * REVEAL: “The serum creatinine level is 0.4 mg per deciliter, and urinalysis reveals 4+ protein and no blood or bacteria. A 24-hour urine collection REVEALS proteinuria (10g per day).” Chúng ta có “công thức” đơn giản sau đây: [Xét nghiệm] show/reveal [danh từ chỉ sự bất thường] Đôi khi chúng ta có thể sử dụng cấu trúc khó hơn một tí ti để bổ sung thông tin cụ thể cho kết quả xét nghiệm, như khi muốn nói rõ số lượng bạch cầu của bệnh nhân là bao nhiêu, như trong ví dụ sau: His CBC shows a leukocyte count of 2800. His/her ___ shows/reveals ____ of ____ “Thyroid studies reveal a TSH of <0.01"


Naïve thường được dịch sang tiếng Việt là ngây thơ. Nếu các bạn mở từ diển Cambridge để tra cứu nghĩa của từ này, các bạn sẽ thấy người ta có ghi chú thêm trong định nghĩa, là “People are often naïve because they are young and/or have not had much experience of life”. Có nghĩa: naïve là chưa từng trải, chưa trải qua một cách gì đấy. Và đó chính là nghĩa mà bạn có thể gặp trong ngữ cảnh y khoa. Trong tiếng Anh y khoa, các bạn có thể gặp những compound adjective như “drug-naïve” hay “treatment-naïve”. Vận dụng định nghĩa mà chúng ta vừa phân tích, có thể hiểu rằng treatment-naïve patients là những bệnh nhân chưa được điều trị trước đó, là previously untreated patients. Drug-naïve patients là những bệnh nhân chưa điều trị thuốc trước đó, hoặc tính từ này cũng có một nghĩa khác là “chưa lờn thuốc”. “Drug naivety” là tình trạng chưa lờn thuốc. Do vậy, nếu gặp trong ngữ cảnh y khoa, đừng hiểu cứng nhắc naïve là ngây thơ, mà hãy hiểu rộng ra là chưa trải qua gì đấy.


Có lẽ để diễn tả khái niệm xét nghiệm chẩn đoán thì ai cũng biết đến từ "diagnostic test". Tuy nhiên nếu chúng ta muốn sử dụng một số từ vựng khác để thay đổi thì thế nào nè? Trên trang cancer.gov https://l.facebook.com/l.php?u=https%3A%2F%2Fcancer.gov%2F%3Ffbclid%3DIwAR0KDLED8rh05yLWq_-Yj70zuaS2PmszhVfN3vmYTRaNGD7q1sZ3DVJ4GRE&h=AT12rk9u1MndvEmtXkfdwBXOlwwUmhtdpTRD2kEHghkuaO1-uwNxZCMp3OX449TmUP52bwD1WU6cnc31EzsLTLOj28KvNauwA1ilFHqAEJqjDg9WT87LVgsw6nFIvjI-doCy1Q2fVgJTG_oZ_6OT_t0GYeYNEy7uyTk8gFvRmCrqyUY-jQNaRLk1i2JM2ymN0l9DRwoPLckrrEu-S3triOcIogHZBAR07xtZ821eQkk1s5cHkjzikuYjcsOBr7Ef3NEdU3hMSJdW0WX6pP8thQdtiZUP2Hac32sJL4H7VShil2FXK0vFkkITuQZA3R6q9cLV7Os6l6rurmdHYJSi2xBXiikWbG6xnXJaf0q1wR3qh5wKTI9fBkVns7O5VpxFwAkuArE_gN47GcvQEiqjXSfCnlUbzLLCBx46amfr-tG-SWg1iP-4jRTzxuyPQ8Rz1yomzUh2WDgi2pgw6zb_MW40lkizhfqqefLDUG5VBYTI83p9IRoDUOo_i5O7WL-b7MXDCX_OGIJ-kOcOPZY3bcCiudkPhroowgUyDk4vfY7tmu4n-ZNE3QPKwINAYmi7XHOkt4P1M2dsjglG7gTjAEDIoznYY6ImaL4YHGeC64Sg_Fs0buyUWQsW915WCEOGeN1JOg, người ta định nghĩa "diagnostic test" là "A type of test used to help diagnose a disease or condition." Từ đồng nghĩa của "diagnostic test" được đưa ra là "diagnostic procedure". Nếu bạn thường xuyên tra cứu trên Medscape, các bạn sẽ thấy một từ khóa thường xuyên xuất hiện, là "work-up", cũng là từ gọi chung cho các xét nghiệm chẩn đoán, bao gồm cả "laboratory studies" và "imaging studies". Bởi vậy nếu bạn muốn nói về những xét nghiệm cho bệnh nhân thiếu máu tán huyết, hãy nói là "workup for hemolytic anemia". Nếu muốn nói về những xét nghiệm ban đầu cho một cái gì đấy, hãy sử dụng cụm từ "initial workup for...". Có một từ khác, cũng sang chảnh không kém mà các bạn có thể sử dụng để nói về những xét nghiệm chẩn đoán là investigation.


Khi đọc các bệnh án viết bằng tiếng Việt, đôi khi chúng ta gặp một cụm từ viết tắt là CRNN, có nghĩa là "chưa rõ nguyên nhân", có thể là tổ hợp triệu chứng không điển hình cho một nguyên nhân bệnh nào, hoặc vẫn còn đang chờ thêm kết quả xét nghiệm để chẩn đoán xác định. Ví dụ "Khó thở CRNN" = "Khó thở chưa rõ nguyên nhân" Vậy CRNN phiên qua tiếng Anh là thế nào các bạn nhỉ? Phiên qua là cụm từ NYD các bạn nhé. NYD là viết tắt của "Not yet diagnosed", ví dụ như đau ngực chưa rõ nguyên nhân sẽ được viết là "Chest pain NYD". Hoặc các bạn cũng có thể sử dụng cụm "of unknown etiology" hoặc "of unknown cause".


Hôm nay chúng ta cùng làm quen với một số cách diễn tả khái niệm cấp trên nền mạn nhé. Hiểu nôm na là bệnh nhân đã có một bệnh nền mạn tính gì đó rồi, sau đó có một nguyên nhân cấp tính xảy ra, làm bệnh lý nền nặng lên đột ngột biến thành một đợt cấp. Trong suy tim người ta có khái niệm suy tim cấp mất bù trên nền suy tim mạn, thường cụm từ tiếng Anh chỉ khái niệm này sẽ là "(acute) decompensated heart failure". Cụm này có thể có acute hoặc không, tuy nhiên phải có decompensated (mất bù) vì đây là từ khóa cực kỳ quan trọng. Tuy nhiên trong bệnh phổi tắc nghẽn mạn tính thì người ta không dùng chữ decompensated, mà thường dùng chữ exacerbation để chỉ những đợt cấp. Ví dụ: Chronic obstructive pulmonary disease with acute exacerbation, hoặc acute exacerbation of chronic obstructive pulmonary disease. Suy thận là một trường hợp mà thuật ngữ tiếng Anh của cấp trên nền mạn cũng gần giống như tiếng Việt: acute on chronic renal failure (AoCRF). Và đôi khi người ta cũng có thể sử dụng cụm từ "on top of" để diễn tả khái niệm cấp trên nền mạn.


Trong bài hôm nay, chúng ta sẽ cùng tìm hiểu về cụm "in the setting of..." Một số cụm/câu tiếng Anh trong bài: - "Bleeding in the setting of anticoagulation." (Xuất huyết trên bệnh nhân đang dùng kháng đông) - "urinary tract infection in the setting of Foley catheter" (nhiễm trùng đường niệu trên bệnh nhân đang đặt sonde tiểu). Trong tình huống này, "in the setting of" được sử dụng để dẫn yếu tố nền có liên quan đến chẩn đoán. Cụm từ này không mang hàm ý "đổ lỗi", mà người viết hay người nói ở đây chỉ đang "nghi ngờ mối liên quan" giữa yếu tố nền và chẩn đoán. Do đó, "in the setting of" trong tình huống này mang ý nghĩa "in patients with" hay "when the patient has". Đơn giản vậy thôi. Nếu như muốn khẳng định yếu tố nền là nguyên nhân của bệnh, chúng ta sử dụng "due to" hoặc "secondary to". Ví dụ khác: - Treatment is indicated in the setting of severe, recurrent infections.


“Status post” là một cụm từ hay được sử dụng trong cả văn nói và văn viết y khoa. Nghĩa của cụm này đơn giản là “after”. Ví dụ: Mrs. Smith is status post cholecystectomy = Mrs. Smith has had her gall bladder removed (Smith, bệnh nhân nữ đã được phẫu thuật cắt bỏ túi mật). Cụm này thường được sử dụng để chỉ một thủ thuật, phương pháp điều trị nào đó đã được tiến hành. Thậm chí cụm này cũng có thể được sử dụng để chỉ tiền căn (this is a 60 yo female status post CVA in 2000). Muôn vàn công năng. Một số ví dụ khác: - status post mastectomy = bệnh nhân đã phẫu thuật đoạn nhũ - 6 days status post colon resection = bệnh nhân phẫu thuật cắt bỏ đại tràng 6 ngày trước - 2 years s/p radiation for bone cancer = xạ trị 2 năm trước Trong các medical note, “status post” thường được viết tắt là s/p. Ví dụ: The patient has a history of 2 cerebrovascular accidents. = Pt s/p CVA X2


Bạn có biết rằng ý nghĩa của "investigation" có thể liên quan đến xét nghiệm? Từ vựng: - Epidemiological investigation - This patient was referred to our hospital for further investigation and management of gastrointestinal bleeding. - Principal investigator


Cùng tìm hiểu về từ "over" trong tập ngày hôm nay nhé. Hãy cùng xem và phân tích ví dụ ở dưới đây nhé. The approved dose of ipilimumab is 3 mg/kg infused over 90 minutes; however, in clinical trials, 10 mg/kg has also been infused over 90 minutes. At this higher dose, patients receive 3 mg/kg within the first 27 minutes of treatment. We sought to determine whether the standard dose of 3 mg/kg could be safely infused over 30 minutes.


Trong tập hôm nay, chúng ta sẽ cùng tìm hiểu về công thức máu. Từ vựng: - Complete blood count, full blood count, CBC with differential, CBC with diff - Red blood cell, white blood cell, platelet - Red cell indices, normal range, reference range


Trong tập ngày hôm nay chúng ta sẽ cùng tìm hiểu về cụm từ giúp mô tả tiền căn đang được kiểm soát tốt với thuốc. Ổn với thuốc thì có nghĩa là đang được kiểm soát tốt với thuốc, nên cụm mà chúng ta cần ghi nhớ là "controlled with medication(s)". Ví dụ: "A 65-year-old woman with a history of hypertension and hyperlipidemia, BOTH CONTROLLED WITH MEDICATION, presents to her cardiologist for a yearly physical examination. Một ví dụ khác có sử dụng cụm này: "Our results suggest that hypertension is not adequately controlled with medication in many parts of the world."